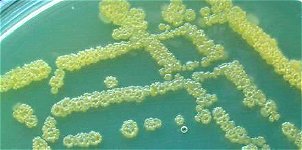
bacteris.jpg

Category Archives: ABP: proposta de treball
Potència contractada

Jaume Casasola i Xavier Rosell. Acabo d’independitzar-me dels meus pares juntament amb dues amigues més: la Gemma i l’Elena. Entre les tres hem decidit llogar un pis força vell a la Verneda…
Transferència de calor

Jaume Casasola i Xavier Rosell. Ahir a la tarda va ploure de valent. Feia dies que no plovia tant. Vaig arribar a casa amb les sabatilles d’esport ben molles i avui tenia classe d’educació física i em feien falta….
Un experiment amb bacteris
Jaume Casasola i Xavier Rosell. Estem fent un experiment amb bacteris. Aquests bacteris es dupliquen cada 24 hores. A primera hora d’un dia de la setmana col·loquem un nombre primer de bacteris en un recipient. Tornem a finals del diumenge següent i trobem exactament 660 bacteris…
La corona de Hieró
